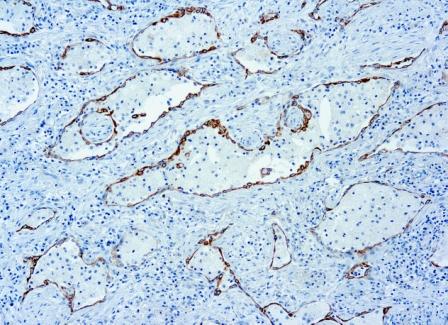

PD1, or CD279/PDCD1 (programmed cell death-1 protein), is a type I transmembrane receptor expressed on activated T-cells, B-cells, and myeloid cells. Engagement of PD1 by its ligands PD-L1 or PD-L2 transduces a signal that inhibits T-cell proliferation, cytokine production, and cytolytic function. Anti-PDCD1 is a marker of angioimmunoblastic lymphoma.also produce responses in nonimmunogenic cancers such as non small cell lung and colon cancers, broadening their scope beyond classic immunogenic tumors like melanoma and renal cell cancer.
0,5 ml
| Clone | DBM15.5 |
| Isotype | IgG1, kappa |
| Application | IHC |
La documentación estará disponible en breve, mientras tanto, puede contactarnos por correo electrónico a specialist@histoline.com